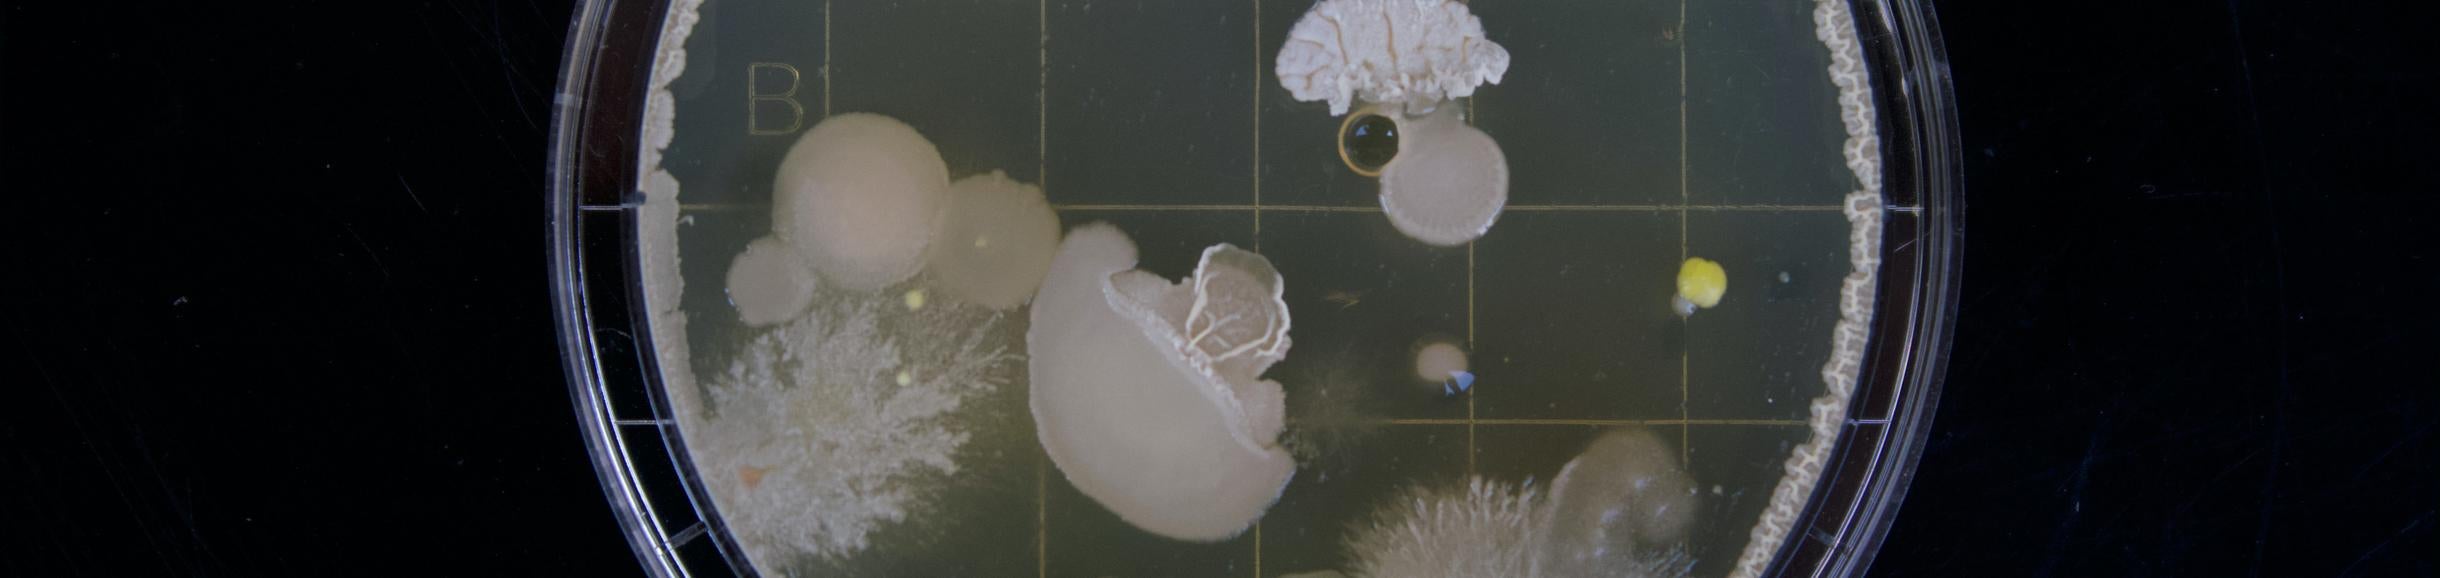

Career Day
In 2011 IIGB initiated Career Day, a biennial, full-day program for graduate students and postdoctoral researchers offering a variety of speakers from diverse backgrounds and science-related careers, as well as useful advice for securing employment in academic and non-academic scientific careers
Regional and State Science Fairs
Our Institute and Centers sponsor awards at Regional and State Science Fairs, and our faculty provide judging for regional competitions. Find out more information about the student awards sponsored by CEPCEB here